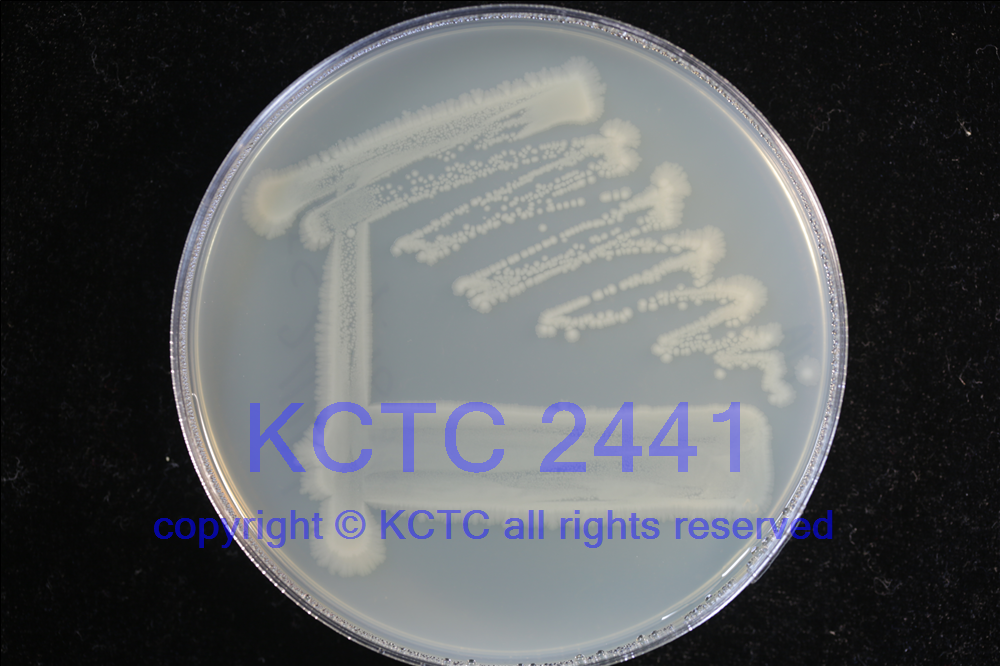

KCTC No.2441
(KCTC Other No.)
Resource TypeBacteria
NameEscherichia coli
Type StrainYes
Biosafty Level1
LMONo
Synonym"Bacterium coli commune", "Bacillus coli", "Bacterium coli"
Phylum (ex Phylum)Pseudomonadota (Proteobacteria - Gammaproteobacteria)
Genome InformationNCBI Genome UID : GCA_003697165.2
JGI Genome ID : Gp0359189
History<- HE Han <- Dept. Microbiol. Seoul National Univ.
SourceFrom urine [1103]
Other Collection No.ATCC [11775], CCM [5172], BCRC [10675], CCUG [24], CCUG [29300], CIP [54.8], CN [4382], DSM [30083], IAM [12119], JCM [1649], LMG [2092], NBRC [102203], NCCB [54008], NCDO [1989], NCIMB [11943], NCTC [9001]
Reference1
KCTC Media No.KCTC media No. 1 Nutrient Agar
Oxygen RequirementAerobic
Temperature37 ℃
pHnetural pH ?? ?? (???? ??)
Incubation Time1 d [???? ???? ????? ??, ?? ? ????? ??? ?? ?? ? ??]